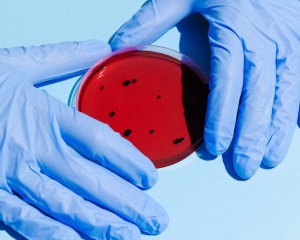

За минувшие сутки в мире зарегистрировали 83,257 новых случаев заражения коронавирусной инфекцией. От осложнений, вызванных болезнью, умерли 5215 человек.
Такие данные сайта Worldometers, который регулярно обновляет статистику зарегистрированных случаев.
По количеству летальных исходов первенство возглавляет США. Там умерли 1691 человек. В Великобритании жертвами болезни стали 621 человек, в Италии - 474, в Бразилии - 340, в Эквадоре - 308, в Испании - 276, в Канаде - 175, во Франции - 166, в Мексике - 113 и 100 жертв в Индии.
ЧИТАЙТЕ ТАКЖЕ: Коронавирусом заболели более 2,5 тысяч российских военных
Больше всего новых случаев коронавируса подтвердили в США - 29,7 тыс. В России обнаружили 9,6 тыс больных, в Великобритании - 4,8 тыс, в Бразилии - почти 4,5 тыс, в Испании - более 2,5 тыс, в Индии - 2,4 тыс, в Перу - более 2 тыс и 1,9 тыс в Турции.
Общее количество больных Covid-19 в мире может составлять как минимум 100 миллионов человек. Официальная статистика инфицированных может быть занижена в 10-12 раз из-за того, что большинство из них не обращаются за медицинской помощью.
Комментарии